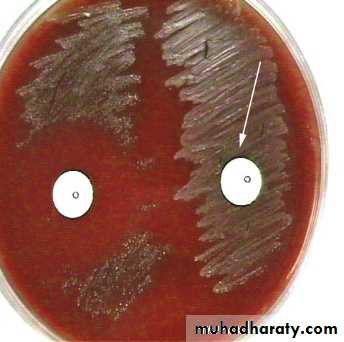
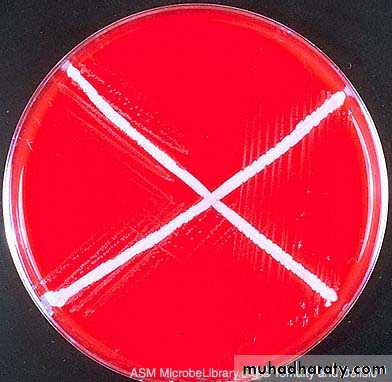

Fifth stage
Surgery(orthopedics)Lec-3P1
د.مثنى
18/10/2016
InfectionAcute haematogenus osteomyelitis.
Subacute haematogenous osteomyelitis.
Chronic osteomyelitis.
Post-traumatic and post operative Osteomyelitis.
Acute suppurative arthritis.
Septic bursitis.
Tuberculosis.
Duration:
acute (less than 2 weeks),Subacute ( 2-6weeks)
chronic (>6 weeks)
Acute haematogenus osteomyelitis.
Inflammation of the bone and its content.
Acute pyogenic infections:
are characterized by formation of pus (concentration of defunct leukocytes, dead and dying bacteria and tissue debris.).
which is often localized in an abscess.
A O M :
is almost invariably a disease of children.When it is occurring in the adult there may be predisposing factor:
low resistance due to debility disease (diabetes).Or drug(immunosupression ).
Causative organism
The causal organism is usually :Staphylococcus aureus.
streptococcus pyogenes ,strep.pnenmoniae.
In children > 4 years age:
Haemophilus influenza,
E.Coli,
pseudomonas aeruginosa
proteus miribilis and
anaerobic bacteriods fragilis.
salmonella in sickle cell infection.
Haemophilus influenza
Haemophilus influenza
E.Coli
E.Coli
Route of entry:
Infection may reach the bones and joints via1.The blood stream from the distant site (boil, tooth infection).
2.Or direct invasion from skin puncture.
Pathology
The most common site is the metaphysis of the long bone particularly around the knee joint.
There are peculiar arrangements of the blood vessels in that area :
the non –anastomosing terminal branches of the nutrient artery twist back in hairpin loops arrangements of capillaries slow down the rate of blood flow before entering the large network of sinusoidal veins
The relative
vascular stasis favors bacterial colonization.
In infant
there is still a free anastomosis between metaphyseal and epiphyseal blood vessel.In adult
haematogenous infection is more common in the vertebra than in long bones
The sequence of the pathological changes as follow.
Inflammation.Suppuration during (2,3 days).
Necrosis due to increasing (intraosseous pressure ).
vascular stasis .
infective thrombosis.and periosteal stripping increasing compromise the blood supply, by the end of a week there is usually evidence of necrosis.
Pieces of bone may separate as SEQUESTRA which act as a foreign body causing Persistant discharge through a sinus until they removed.
Finally, it may through the skin to the surface and form a chronic sinus becoming a persistent sinus tract or cloacae.
reactive new bone formation
resolution, healing.
Location of infection
Children : primarily in the long bones
(femur, tibia, fibula, humerus).
Adults :(50-60s) - primarily vertebrae.
Neonates : have multiple bone infectious sites
Clinical features history
The onset is rapid and attacks in short time.The patient, usually a child or adolescent,.
complains a severe pain in a limb, and the pain is not relieved by rest.
A complete history and physical examination are required to search for possible primary foci of infection.
There may be some minor injury or insignificant infective lesion such as boil sore throat a few days earlier
The general symptoms of toxemia:
①severe acute illness appear
②irritable and restless
③high fever, chill
④rapid pulse, nausea, vomiting etc
local signs
caloric, rubor, dolor, tumor.Heat, red, pain or tenderness, swelling.
Initially, the lesion is within the medually cavity, there is no swelling, soft tissue is also normal.
The merely sign is deep tenderness.
Localized finger-tip tenderness is felt over or around the metaphysis.it is necessary to palpate carefully all metaphysic areas to determine local tenderness.
pseudo paralysis .
Subperiosteal abscess formation
Edematous, red and fluctuationindicating Subperiosteal abscess formation.
As the Subperiosteal abscess formed, signs of inflammation followed rapidly.
The extremity is held in semiflexion.Surrounding muscles are in spasm .
Passive movement is resisted
An increase effusion in the adjacent joint proves in most cases to be a sympathetic synovitis with sterile clear fluid.
Hydroarthrosis should not be confused with septic arthritis.
It is important to remember that the metaphysis lie within the joint capsule of the hip, shoulder, ankle.
Therefore these joints can develop septic arthritis by extension of Osteomyelitis.
If the infection and septicemia proceeded unabated, the patient may have toxic shock syndrome.
Differential diagnosis:
1. Cellulites
(wide spread superficial redness and lymphangitis).
2.Acute suppurative arthritis.
3.Acute rheumatism (flitting joint pain).
4.Sickle-cell crisis.
5.Gauchers’ disease.
Laboratory findings:
The white blood cell count will show a marked leulocytosis as high as 20,000 or more.
The blood culture demonstrates the presence of bacteremia, the blood must be taken when the patient has a chill, especially when there is a spiking temperature.
Aspiration.
The point of maximal tenderness should be aspirated with a large-bore needle.Any material aspirated should be gram stained and cultured to determine the sensitivity to antibiotics.
C - reactive protein :
is specific for the diagnosis with high reading.
X-ray finding:
x-ray films are negative within 1-2 weeks,Although carefully comparison with the opposite side may show abnormal soft tissue shadows.
It must be stressed that x-ray appearances are normal in the acute phase. There are little value in making the early diagnosis.
Radiography not appear till after 3 weeks.
decrease bone density moth eaten.later on new bone formation.
Early diagnosis depends on followings:
1. severe acute illness, rapid onset and toxemia.2. local severe pain and unwillingness to move limbs.
3.deep tenderness.
4.WBC count is as high as 20,000 or more .
5.Every effort must be made to obtain a bacterial culture and determinate the sensitivity to antibiotics.
Tc99m scanning.
CT or MRI.
Treatment
1.General treatment:nutritional therapy or general supportive treatment by intaking enough caloric, protein, vitamin etc.
2. antibiotics therapy.
3.surgical treatment .
4.immobilization .
Antibiotics therapy
The prompt administration of antibiotics is so vital that the result need not be waited, usually using wide-spectrum antibiotics, even by intravenous administration during the first 1-3 days.
The choice of antibiotics may subsequently be modified according to culture, sensitivity results, and clinical response.
The treatment should be continued for at least 2 weeks after the body temperature is down to the normal in order to minimize the possibly of reoccurrence.
Surgical treatment
As any infection in a closed space, immediate provision of drainage is of paramount importance.This must be done at earliest possible opportunity even before signs of Subperiosteal abscess is evident.
To wait is to invite disaster.
Surgery is indicated when there has been no response to vigorous antibiotics treatment after 48-72 hours.
Surgery is achieved by making a window in the bone cortex to decompress rather than debridement.
Complication
Spread septicemia.Persistant infection (chronic).
Growth disturbance shortening or deformity.
. suppurative arthritis:
(in young children in intracapsular metaphysis.).